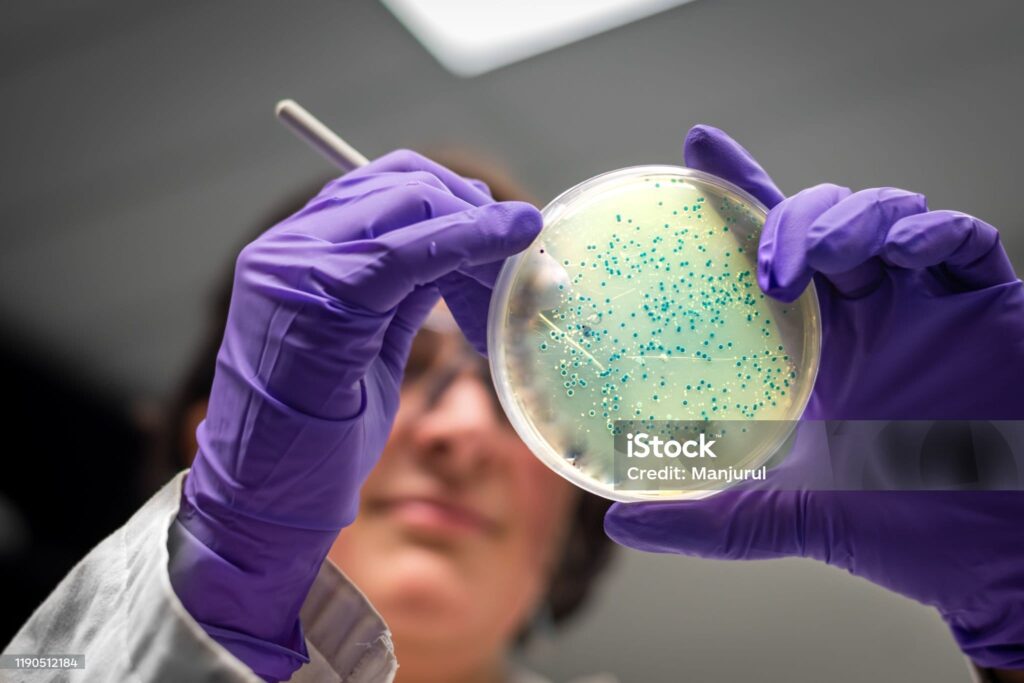

NVON
TOA – de spil van het practicumonderwijs
Wat heeft de NVON jou te bieden:
De NVON ondersteunt TOA’s met praktische kennis, professionele ontwikkeling en een sterk netwerk. Via het TOA-handboek, de website en veiligpracticum.nl vind je direct bruikbare informatie voor het practicum.
- Jaarlijks TOA-congres met workshops en inspiratie
- Praktische tools en veiligheidsinformatie voor het practicumlokaal
- Netwerk en uitwisseling met collega-TOA’s
- Meedenken over opleidingen, ARBO en de toekomst van het vakgebied
- Betrokkenheid bij commissies en onderwijsontwikkelingen (o.a. bovenbouw en NLT)

TOA’s zijn sterk vertegenwoordigd binnen de NVON en hebben een eigen actieve sectie. Zij vergaderen een aantal keer per jaar en organiseren diverse activiteiten en voorzieningen voor het practicumonderwijs. Zo blijf je betrokken, geïnspireerd en verbonden met collega’s uit het hele land.
Wil je meer weten?
Mail: toa@nvon.nl
Tips en ervaringen uitwisselen
Het FORUM is voor en door toa’s. Maak een account aan en doe mee. Als je NVON lid bent, vul dan je NVON lidnummer in.
Veilig praktijklokaal
Alles wat je nodig hebt om practica veilig te organiseren: praktische tips, richtlijnen en hulpmiddelen voor een veilig en verantwoord praktijkonderwijs.
Kijk op:
Veiligpracticum
Ben’s linke soep
Arbocatalogus-VO
Veilige praktijklokalen
VO-signaal: Veilig inzetten van lasers in en rond het klaslokaal | Voion
Practica in beeld
Ontdek alle practica voor scheikunde, natuurkunde en biologie op één plek. Inclusief beschrijvingen, benodigd materiaal en handige tips om ze direct in de klas of het practicumlaboratorium toe te passen.
TOA-congres
Het jaarlijkse TOA-congres biedt workshops, netwerkmogelijkheden en inspiratie voor iedereen in het practicumonderwijs. Ontdek nieuwe werktrucs, deel ervaringen en blijf op de hoogte van de laatste ontwikkelingen in het vakgebied.
TOA-nieuwsbrief
TOT – TOA Ontwikkel Team
Regionale teams van TOA’s delen kennis, werken samen en ontwikkelen nieuwe ideeën voor het practicumonderwijs.